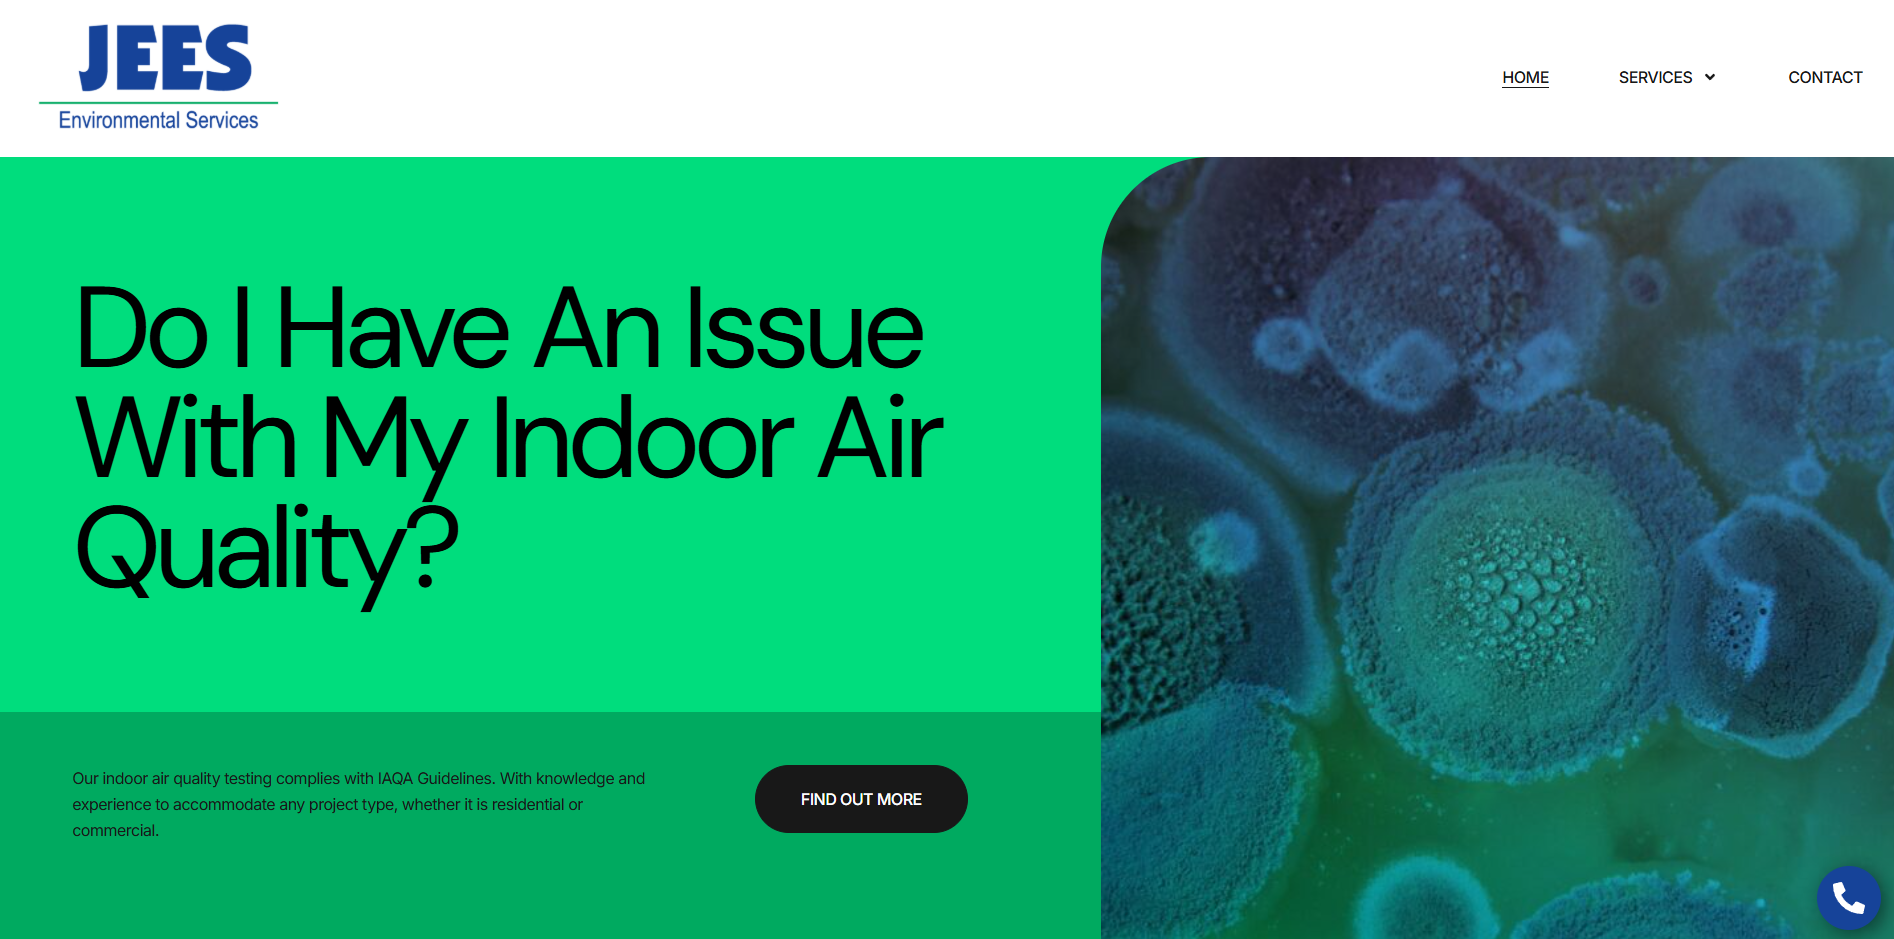
Gallery thumbnail

yext
Fisher Tech Solutions LLC Owner verified
14 Main St Wales, MA, 01081Last time updated: 3/3/26, 10:19 AM
About
Fisher Tech Solutions specializes in providing small to medium sized businesses with the highest quality Web Design and Development services as well as SEO, Web Hosting, E-Commerce and online marketing solutions.
Images

Frequently Asked Questions
Which days is Fisher Tech Solutions LLC open?
Open on Monday, Tuesday, Wednesday, Thursday, Friday, Saturday, Sunday.
Attention business owner!
Register your business now and enhance your global reach with iGlobal.
Copied to clipboard!